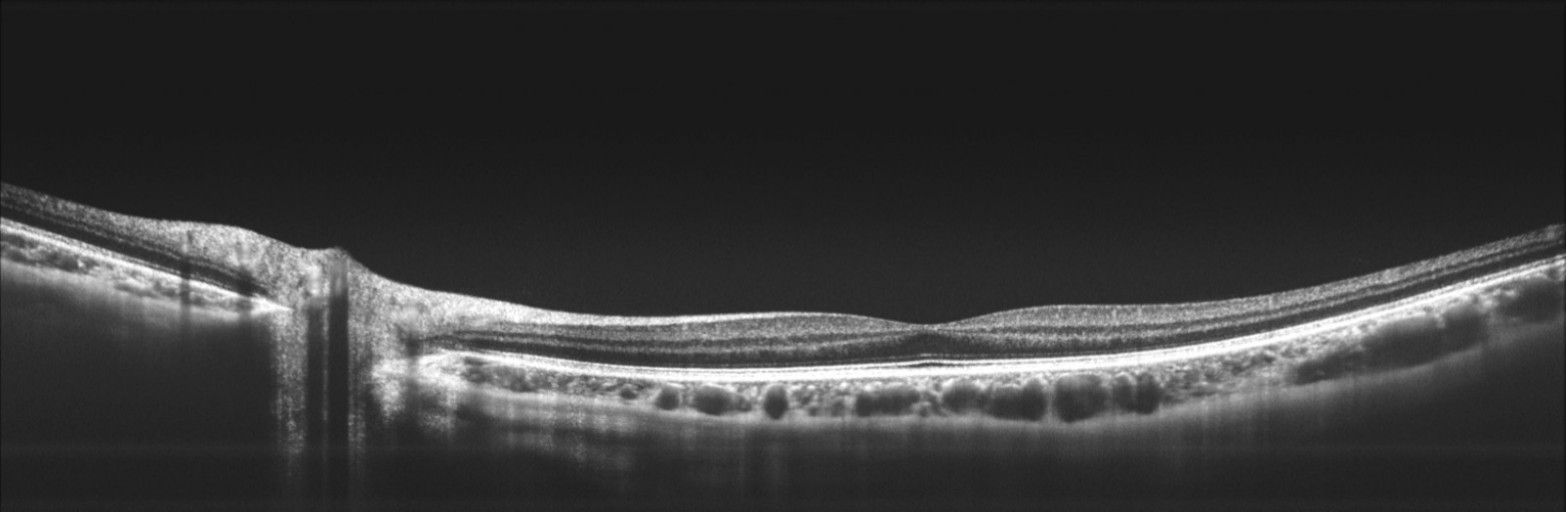

想完成中高端眼科器械的进口替代,「图湃影像」自主研发扫频 OCT 视网膜诊断系统
光学相干断层成像术(optical coherence tomography,OCT)是一种高分辨率,非接触性、无创的生物组织成像技术,使医生能够无创地获得视网膜断层影像。该技术从20世纪90年代初开始应用于眼科临床,并完成了从时域OCT、光谱OCT 、扫频OCT的三代技术更迭。 目前中国眼科OCT的中高端市场完全被进口产品垄断,譬如德国Zeiss和Heidelberg、日本Topcon、美国Optovue等;国产产品在性能参数上与进口产品有较大差距。
作为最新一代的OCT技术,扫频OCT扫描速度更快、成像深度更深;但由于眼科扫频OCT研发成本高、难度大,目前在中国眼科医疗市场上光谱OCT还是占主流。目前全球仅有德国Zeiss、日本Topcon取得了眼科扫频OCT的注册证并实现了量产,仅有Topcon在中国取得注册证并实现了销售。据悉,2018年中国眼科OCT销售量约1500-2000台,其中Topcon的眼科扫频OCT相关型号产品就卖出近百台。「图湃影像」联合创始人王颖奇认为,扫频OCT是眼科医疗领域未来的技术趋势 。
图湃影像是36氪近期接触到的一家专注于眼科扫频OCT的研发型企业。据王颖奇介绍,公司的首款眼科OCT视网膜诊断系统——超高速扫频OCT产品Sigma-1000/2000型号已开发完成,它支持眼底OCT血流成像功能(OCTA),且配备了高精度的眼底辅助定位系统及强大的图像分析系统,预计将在今年9月取得注册证并正式发布。
Sigma-1000样机(团队供图)
王颖奇介绍到,以上性能参数的实现在于公司攻克了以下三个方面的难点:
扫频OCT系统研发:扫频OCT是最新一代OCT技术,因此在充分理解系统理论基础上进行设计、装配、调试的难度较大;
核心底层基件的自主研发:扫频OCT由诸多核心光电器件组成,这些器件目前的国产化率非常低。图湃影像通过与清华大学的合作,突破了该领域的诸多技术工艺难点,实现了大部分器件的自主设计开发,有效降低了整机物料成本,也提升了供应链的稳定性;
成像系统:目前中国在光学成像领域整体落后,而眼底成像要求产品的空间光学系统能与眼球的光学结构有非常好的匹配,对光学设计有很高要求。图湃影像团队在这一领域形成了一套自主解决方案。
16mm视盘-黄斑区断层成像(团队供图)
黄斑区OCTA成像效果(团队供图)
王颖奇透露,公司已初步建立了研发生产线,并与国内光电制造业多家企业达成了合作。他还表示,眼科OCT产品应用到了一系列平台性技术,这些技术在多种光学医疗设备上均可以得到应用。因此,未来图湃影像将布局更多光学医疗设备,并推动上游产业的发展。
不过,有了产品后要打通医疗渠道也是难点。王颖奇坦言,过去两年公司一直将重心放在提高参数、打磨产品以提升整体的用户体验上,通过清华学术平台与清华长庚医院、协和医院等多家知名医院开展学术合作,基于医生帮助来提升产品的易用性;经过2年多的市场调研及反馈,图湃也已制定出自己的市场运营战略并组建了专家级市场运营顾问团队。
从市场端看,目前中国有近1.4亿的眼底病患者,眼科医疗市场的规模超狗1000亿,其中器械类市场规模近100亿,细分领域的OCT市场18年销售额只有约15亿元,看上去并不是那么性感的市场。王颖奇告诉36氪,正因为目前市场被进口设备垄断,缺乏高性价比的产品,导致基层医院普及度不高,大量的眼底疾病患者无法及时、有效的接受OCT检查。若能大幅提升产品的性价比,全面实现进口替代,需求也会很快释放。
他预测,随着OCT设备在一二级医院的普及,以及私立眼科医院、眼视光中心、体检中心数量的快速增加, OCT市场在未来5年内将迎来爆发式增长。
最后介绍一下团队,目前全职员工20余人,以技术团队为主,创始团队均为清华大学校友。首席科学家霍力教授目前任教于清华大学电子系,在光通讯、光电子学等技术领域有二十年的研发经验,在OCT相关技术领域发表论文近百篇;总经理王颖奇毕业于清华大学生物医学工程系,有多年医疗设备系统设计开发经验及团队管理经验;技术总监邢燕飞博士毕业于清华大学电子系,有十余年的光电子领域研发经验;软件算法主管汪霄毕业于清华大学电子系,有多年的图像算法研发经验。
本项目的部分技术雏形来自于清华大学电子系的科技成果转化,创始团队于2016年年底组建,2017年正式注册公司,已先后完成两轮总计数千万元人民币融资。
王颖奇透露,公司会在2019年4月启动A轮融资,用于研发、市场推广和量产等方面。